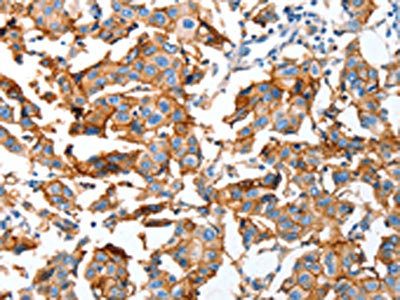

AOX1 Antibody
-
中文名稱:AOX1兔多克隆抗體
-
貨號(hào):CSB-PA267569
-
規(guī)格:¥1100
-
圖片:
-
The image on the left is immunohistochemistry of paraffin-embedded Human esophagus cancer tissue using CSB-PA267569(AOX1 Antibody) at dilution 1/65, on the right is treated with fusion protein. (Original magnification: ×200)
-
The image on the left is immunohistochemistry of paraffin-embedded Human breast cancer tissue using CSB-PA267569(AOX1 Antibody) at dilution 1/65, on the right is treated with fusion protein. (Original magnification: ×200)
-
Gel: 10%SDS-PAGE, Lysate: 40 μg, Lane: Human liver tissue, Primary antibody: CSB-PA267569(AOX1 Antibody) at dilution 1/1000, Secondary antibody: Goat anti rabbit IgG at 1/8000 dilution, Exposure time: 30 seconds
-
-
其他:
產(chǎn)品詳情
-
Uniprot No.:
-
基因名:
-
別名:AOX1 antibody; AOAldehyde oxidase antibody; EC 1.2.3.1 antibody; Aldehyde oxidase 1 antibody; Azaheterocycle hydroxylase antibody; EC 1.17.3.- antibody
-
宿主:Rabbit
-
反應(yīng)種屬:Human,Mouse,Rat
-
免疫原:Fusion protein of Human AOX1
-
免疫原種屬:Homo sapiens (Human)
-
標(biāo)記方式:Non-conjugated
-
抗體亞型:IgG
-
純化方式:Antigen affinity purification
-
濃度:It differs from different batches. Please contact us to confirm it.
-
保存緩沖液:-20°C, pH7.4 PBS, 0.05% NaN3, 40% Glycerol
-
產(chǎn)品提供形式:Liquid
-
應(yīng)用范圍:ELISA,WB,IHC
-
推薦稀釋比:
Application Recommended Dilution ELISA 1:1000-1:5000 WB 1:500-1:2000 IHC 1:100-1:300 -
Protocols:
-
儲(chǔ)存條件:Upon receipt, store at -20°C or -80°C. Avoid repeated freeze.
-
貨期:Basically, we can dispatch the products out in 1-3 working days after receiving your orders. Delivery time maybe differs from different purchasing way or location, please kindly consult your local distributors for specific delivery time.
-
用途:For Research Use Only. Not for use in diagnostic or therapeutic procedures.
相關(guān)產(chǎn)品
靶點(diǎn)詳情
-
功能:Oxidase with broad substrate specificity, oxidizing aromatic azaheterocycles, such as N1-methylnicotinamide, N-methylphthalazinium and phthalazine, as well as aldehydes, such as benzaldehyde, retinal, pyridoxal, and vanillin. Plays a key role in the metabolism of xenobiotics and drugs containing aromatic azaheterocyclic substituents. Participates in the bioactivation of prodrugs such as famciclovir, catalyzing the oxidation step from 6-deoxypenciclovir to penciclovir, which is a potent antiviral agent. Is probably involved in the regulation of reactive oxygen species homeostasis. May be a prominent source of superoxide generation via the one-electron reduction of molecular oxygen. Also may catalyze nitric oxide (NO) production via the reduction of nitrite to NO with NADH or aldehyde as electron donor. May play a role in adipogenesis.
-
基因功能參考文獻(xiàn):
- AOX1 SNPs exist in which the base-pair exchange of the SNP leads to loss of enzyme activity. PMID: 26842593
- ten novel single nucleotide polymorphisms resulting in amino acid exchanges in proximity to the FAD site of hAOX1, were characterized. PMID: 28750088
- Data suggest that substrate specificity of AOX1 includes GDC-0834, an inhibitor of Bruton's tyrosine kinase with potential non-steroidal anti-inflammatory agent activity; in liver cytosol, hydrolysis of GDC-0834 is primarily due to AOX1. PMID: 25845827
- Methotrexate is poorly metabolized by human AOX1, in contrast to rabbit. PMID: 26032640
- These results supported the possibility that XO/XD and AO can contribute to nitric oxide generation. PMID: 25537183
- Several donors have a normal AOX1 protein level. PMID: 23857892
- High AOX1 methylation was associated with biochemical recurrence in prostate cancer. PMID: 23918943
- The physiological role of AOX1 remains unclear, but it is known that thiopurines belong to its substrates; AOX1 contributes to azathioprine catabolism. PMID: 22495427
- hydralazine, at a concentration of 25 to 50 muM, can be used in human hepatocyte incubations to estimate the contribution of aldehyde oxidase to the hepatic clearance of drugs and other compounds. PMID: 22522748
- Human population is characterized by the presence of functionally inactive hAOX1 allelic variants as well as variants encoding enzymes with different catalytic activities. PMID: 22279051
- characterization of AO activity in cryopreserved human hepatocytes: enzyme stability; substrate specificity; kinetics; inhibition by hydralazine PMID: 22031625
- Expressed AOX1 in Escherichia coli and purified kinetically active protein. PMID: 19741035
顯示更多
收起更多
-
亞細(xì)胞定位:Cytoplasm.
-
蛋白家族:Xanthine dehydrogenase family
-
組織特異性:Abundant in liver, expressed in adipose tissue and at lower levels in lung, skeletal muscle, pancreas. In contrast to mice, no significant gender difference in AOX1 expression level (at protein level).
-
數(shù)據(jù)庫(kù)鏈接: